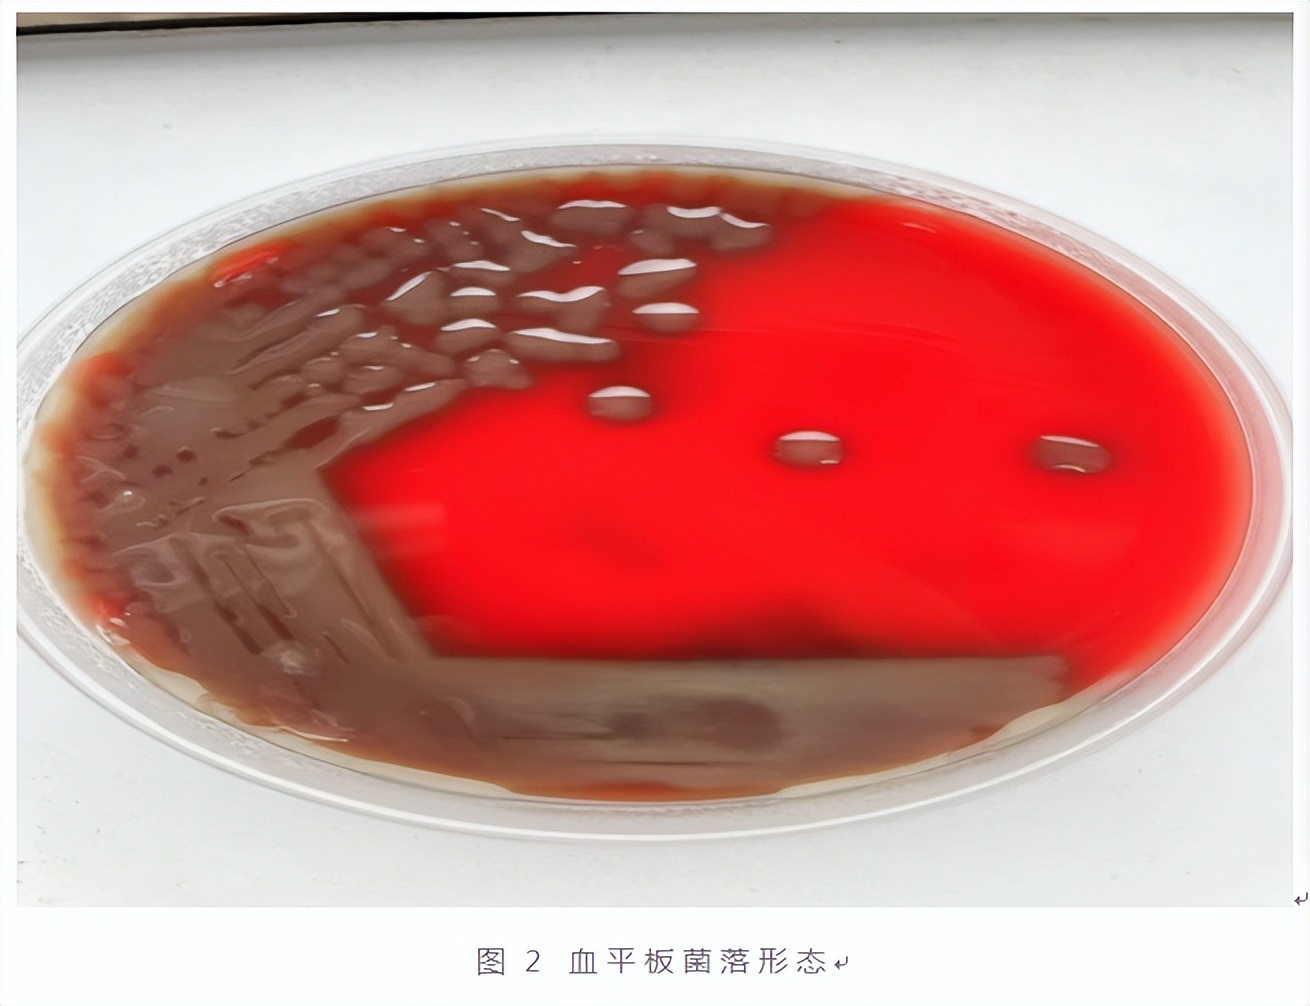

省二院专家提示,高度警惕肺炎链球菌
肺炎链球菌(Streptococcus pneumoniae,Sp)是一种广泛存在于自然界中,常定植于人体上呼吸道的一种革兰阳性球菌,通常不引起人类致病,但免疫力较低的婴幼儿及老年人普遍易感,会引起局部呼吸道感染甚至肺炎。由于肺炎链球菌会产生自溶酶,存在自溶现象,导致该菌分离率降低,而临床中从血液中分离出该菌更是少见。
近日,陕西省第二人民医院(陕西省老年病医院)收治了1例老年肺炎链球菌血流感染患者。患者,男,66岁,因“腹痛”于2024年1月31日入省二院消化内科治疗,入院后查胸部CT提示肺部感染,转至呼吸与危重医学科。
患者有发热症状,结合血象及胸部CT结果医生考虑患者肺部严重感染,为进一步指导治疗及明确有无脓毒血症进行微生物检查,送左右两侧肢体血培养各1套共4瓶送至微生物实验室。培养14小时后,需氧和厌氧血培养瓶均报阳,涂片干燥后进行革兰染色及镜检,为革兰阳性双球菌(图1),检验人员立即以危急值电话报于临床。

将报阳血液接种培养15小时后,血平板上可见湿润的、有草绿色溶血环的粘液型菌落(图2)。

微生物室将血培养鉴定及药敏结果立即报告临床,在临床药师指导下,医生依据药敏结果调整用药方案,在原用药方案的基础上加强抗链球菌治疗。调整治疗方案后,患者感染指标均有下降趋势,其中白介素6下降最为明显,从入院时的90.76pg/mL下降至28.13pg/mL,患者症状明显好转,临床治疗有效,各项指标结果均正常,康复出院。

肺炎链球菌为条件致病菌,近年来随着抗菌药物滥用和环境污染,感染率逐年上升。但因肺炎链球菌菌体具有自溶特性,常造成其分离率降低甚至漏检,而从血液培养中分离出该细菌的病例更是十分少见。随着肺炎链球菌的变异和传播,尤其青霉素不敏感的肺炎链球菌使临床治疗面临严峻考验,由此可见早期及时的血培养及准确的药敏试验的重要性,建议临床面对不明原因的发热病例时,应规范采集、及时送检血培养。(来源:陕西省第二人民医院)
扫一扫在手机打开当前页